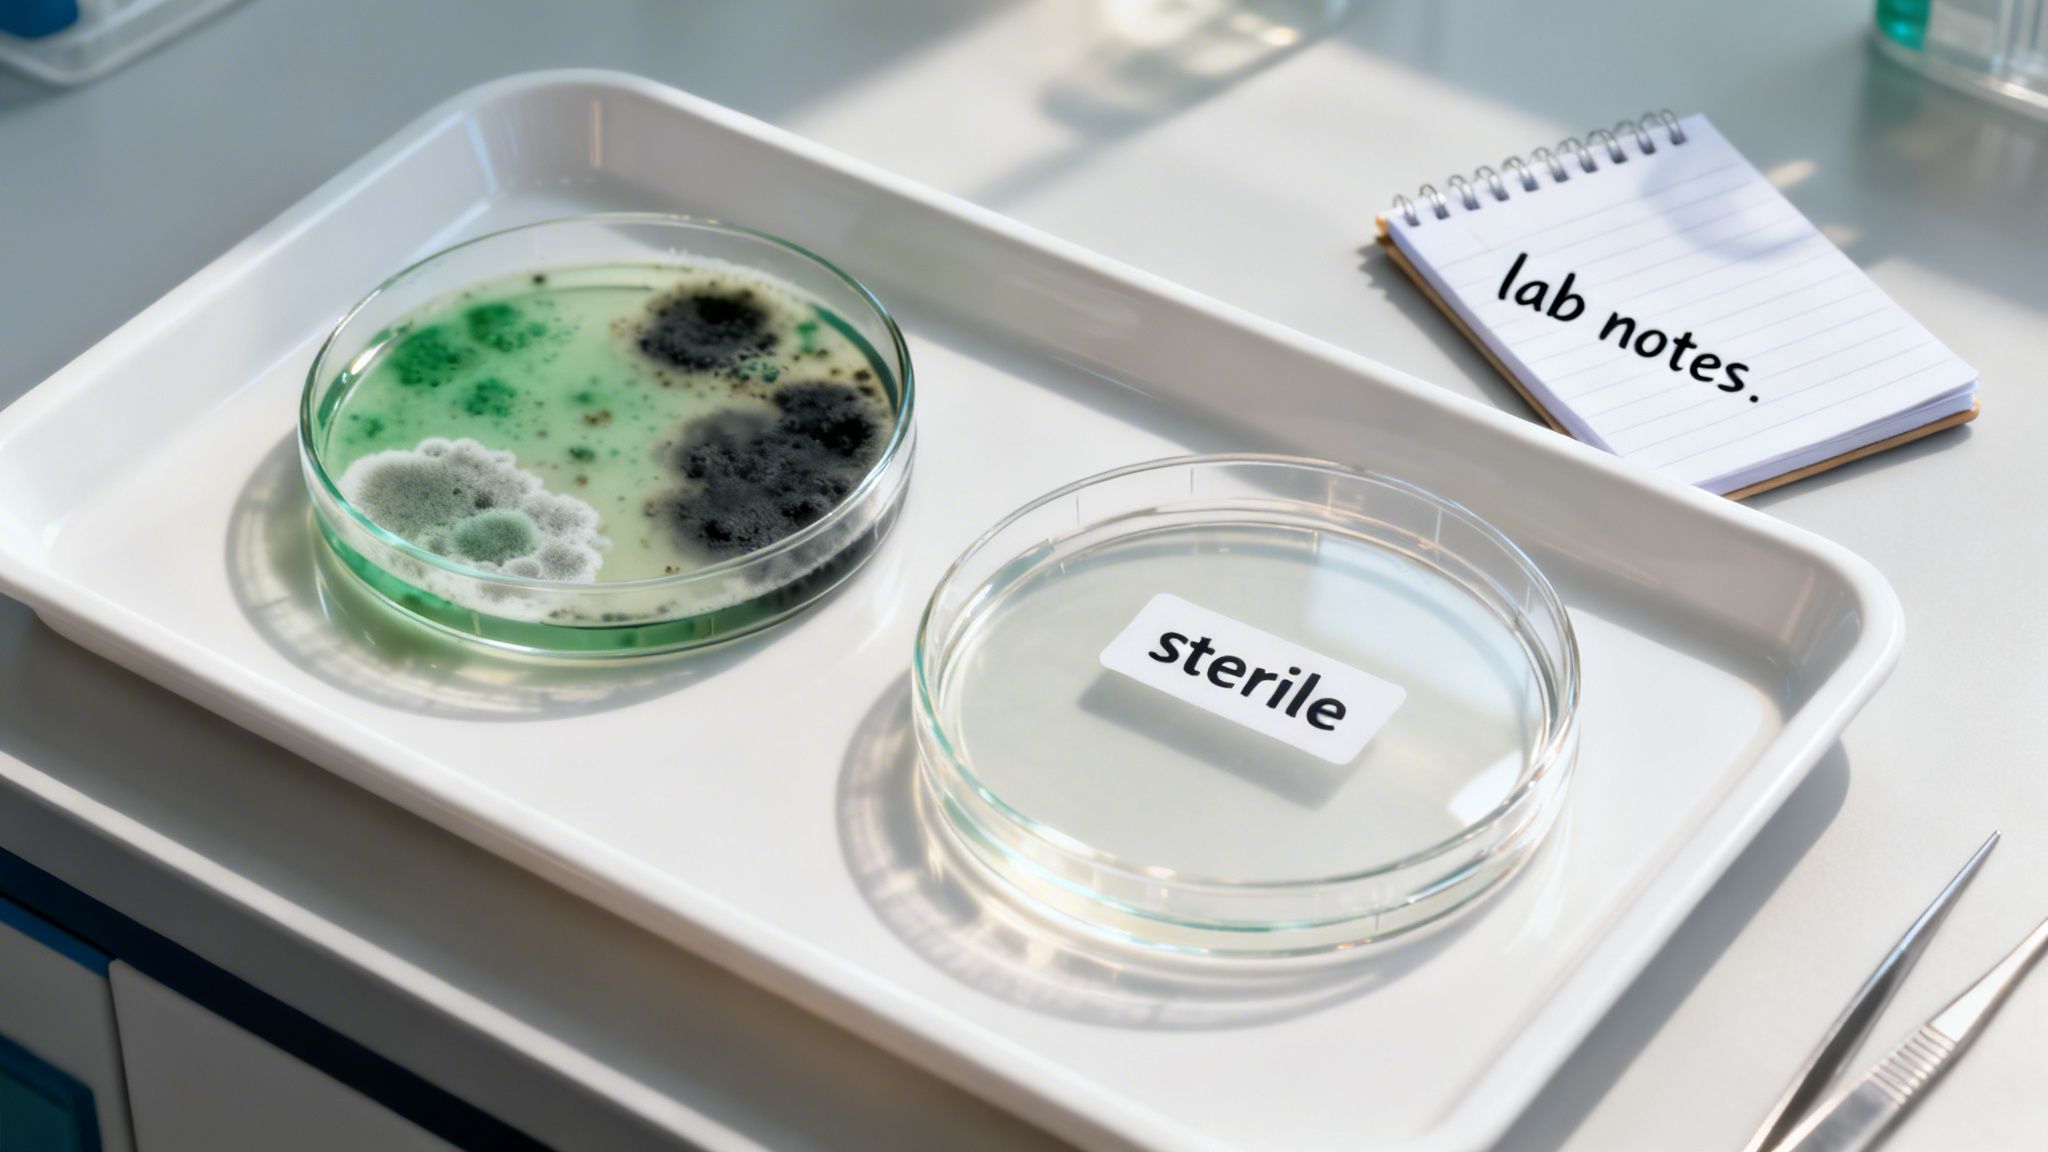
Two petri dishes on a lab tray: one with vibrant mold growth, another labeled 'sterile,' next to 'lab notes' notebook.

So, what exactly is a magic mushroom spore kit? You might see them online and think of them as a simple DIY project, kind of like a gardening starter pack for your windowsill. And in a way, you're right. These kits usually come with everything you think you need to get started: a spore syringe or print, the right growing material, and a container.
What Is a Magic Mushroom Spore Kit Anyway?
On the surface, a spore kit seems like an all-in-one ticket for anyone curious about mycology. But this is where things get tricky. The key component is the spores themselves—microscopic cells that can eventually grow into mushrooms. Because the spores don't actually contain any psilocybin, they're often sold legally across the country for "microscopy" or "research purposes."
This creates a serious legal gray area. While buying the spores might be perfectly fine where you live, the moment you use them for their intended purpose—germinating them to grow mushrooms—you could be breaking federal and state law.
A magic mushroom spore kit is more than just a hobby project; it's an entry into the world of mycology that carries significant legal and practical considerations. The journey from spore to mushroom is one that requires precision, patience, and a clear understanding of the risks involved.
This surge in interest isn't just anecdotal. The global market for mushroom growing kits was valued at USD 417.70 million in 2025 and is expected to hit USD 692.14 million by 2032. You can dig into more of the data on the mushroom growing kits market from 360iResearch, but it’s clear home cultivation is booming.
Ultimately, these kits put consumers in a tough spot. They're legal to buy but often illegal to use. This paradox introduces some major risks you should be aware of:
- Legal Trouble: Even in decriminalized areas like Ann Arbor or Detroit, cultivation can carry legal consequences that personal possession does not.
- Contamination: Growing mushrooms is a delicate science. Without a sterile environment, your kit can easily fail, becoming a breeding ground for mold and bacteria instead of mushrooms.
- Zero Potency Control: If you do succeed, the psilocybin levels in homegrown mushrooms can be wildly unpredictable. You never really know what you’re getting.
This guide will break down these risks in more detail and walk you through safer, more reliable alternatives available for adults in Michigan and surrounding areas.
Navigating the Legal Maze of Spore Kits
The legality around a magic mushroom spore kit is a real minefield, and it’s one of the most misunderstood parts of the psychedelic space. On a federal level, and in most states, the spores themselves are perfectly legal. Why? Because they don’t actually contain psilocybin, the psychoactive compound that’s classified as a controlled substance.
This creates a loophole that allows spores to be bought and sold, but only for a very specific purpose: "microscopy use" or scientific research.
But that protection is thin. It disappears the second you introduce those spores to a growing medium to cultivate mushrooms. At that point, in the eyes of state and federal law, you’re manufacturing a Schedule I substance. The penalties for that can be severe.
Understanding this distinction is absolutely crucial before you even think about buying a kit.

This guide helps break down the choice you’re facing. One path is for legitimate scientific study, and the other points toward safer, legal alternatives if your goal is personal consumption. The big takeaway here is that your intent is everything, and trying to grow your own for personal use is a path filled with legal risks.
Decriminalization Is Not Legalization
You've probably heard that cities in Michigan like Ann Arbor and Detroit have decriminalized psychedelic plants, which is a huge step forward. But it's vital to know what "decriminalization" actually means on the ground.
It means personal use and possession have become the lowest law enforcement priority. It absolutely does not make it legal to grow or sell mushrooms.
This is where people get tripped up. While you might not get in trouble with city cops for having a small personal amount, you could still face charges from state or federal authorities—especially if you're caught cultivating. It creates a very confusing and risky gray area for anyone thinking about a home-grow project.
Choosing to grow mushrooms with a spore kit is a legal gamble. Even with decriminalization in some cities, you're not protected from state or federal manufacturing laws, leaving you exposed to serious consequences.
Instead of trying to walk this legal tightrope, many people are wisely choosing professionally prepared products that are designed to comply with local guidelines. For those genuinely interested in the science—without the legal headaches of cultivation—you can explore psilocybe spore syringes and their intended use for microscopy.
Ultimately, the choice is clear: either engage in legal, hands-off scientific research or find a safer, more reliable path to personal use.
The Hidden Dangers of Home Mushroom Cultivation
Beyond the legal headaches, trying to grow your own mushrooms with a magic mushroom spore kit is a lot harder than it looks. Those slick online tutorials and tidy boxes make it seem easy, but they often skip over the frustrating reality. This isn’t just some fun gardening project; it's a delicate scientific process where so much can go wrong.
The biggest threat to any home grow is contamination. Think about it—your home is filled with invisible competitors. Mold spores and bacteria are floating in the air, sitting on surfaces, and even on your skin. Without a professional-grade sterile setup, like a lab with a laminar flow hood, these invaders can easily get into your grow.
Once contamination sets in, it’s a race your mushroom mycelium will almost always lose. These other fungi and bacteria grow fast, turning your promising project into a fuzzy, discolored mess. Even worse, some of these molds are toxic, creating a serious health risk if you don't spot them.
The Problem of Potency and Purity
Let's say you get lucky and manage to avoid contamination. You're still facing a huge hurdle: consistency. It's like trying to bake a cake without a recipe or an oven that holds a steady temperature. You might end up with something that looks like a cake, but the results are a total gamble.
It's the same with home cultivation. The psilocybin levels in homegrown mushrooms can swing wildly from one batch to the next—and even between mushrooms in the same harvest. This makes any attempt at consistent, safe dosing a shot in the dark.
Home cultivation provides zero guarantees on purity or potency. You're left guessing about what you've actually grown and how strong it is, turning a potential therapeutic experience into a game of chance.
This unpredictability is a major reason why so many people are choosing to leave the DIY route behind. The risks are just too high:
- Contamination Risk: Unwanted mold or bacteria can wipe out your whole batch and could even be harmful to your health.
- Inconsistent Potency: Psilocybin levels can vary so much that you can't achieve a predictable or safe experience.
- Time and Effort: A successful grow takes weeks of careful work and maintaining sterile conditions, with absolutely no promise of a good outcome.
At the end of the day, the appeal of a simple magic mushroom spore kit usually fades when faced with the difficult reality of amateur mycology. For anyone looking for reliability and safety, professionally produced and lab-tested products are the clear, dependable alternative.
Why Dispensary Products Are a Safer and Smarter Choice
After weighing the legal headaches and all-too-common frustrations of growing your own, it’s easy to see why so many people are looking for a better way. A magic mushroom spore kit is a gamble—you're rolling the dice on contamination, legal risks, and potency that's all over the map. It’s a stark contrast to the safety and reliability you get with professionally made dispensary products.
Why leave it to chance when you can choose a guaranteed outcome?
Think about it this way: you could try brewing your own beer in the garage, hoping it doesn't get contaminated and risking a final product that's either too weak or way too strong. Or, you could grab a six-pack from a trusted craft brewery. The smarter, safer choice is pretty clear.
The Guarantee of Safety and Consistency
When you choose a dispensary like Metro Mush, it all comes down to two things that really matter: safety and consistency. Every single product we offer, from dried mushroom strains to our infused chocolates, goes through serious testing to check for purity and measure its exact potency.
This gives you a few key advantages:
- Product Safety: Our lab testing makes sure everything is free from mold, bacteria, and other contaminants that can easily ruin a home grow.
- Consistent Dosing: You know exactly what you’re getting every single time. A 100mg microdose chocolate square is always going to be 100mg, which means your experience is predictable and easy to repeat.
This level of quality control takes all the guesswork out of the equation. You’re not just buying a product; you’re buying peace of mind. If you're curious about what options are out there, our guide on where to buy shrooms in Michigan is a great place to start.
It's helpful to see the differences side-by-side. Here’s a quick comparison of what you can expect from a DIY kit versus a dispensary product.
DIY Spore Kit vs Dispensary Products: A Comparison
| Feature | Magic Mushroom Spore Kit (DIY) | Metro Mush Dispensary Products |
|---|---|---|
| Safety | High risk of mold, bacteria, and other contaminants | Lab-tested for purity and guaranteed free from contaminants |
| Potency | Inconsistent and unpredictable; varies with each grow | Precisely measured and consistent for reliable dosing |
| Legality | Legally gray area; cultivation can carry significant legal risks | Legal to purchase in decriminalized areas like Ann Arbor and Detroit |
| Effort & Time | Weeks or months of labor with a steep learning curve | Ready to use immediately; no effort required |
| Experience | Unpredictable effects; high chance of failure | Consistent, reliable, and repeatable experiences |
| Cost | Initial low cost, but can be expensive with failed attempts | Higher upfront cost, but guarantees a high-quality product |
The takeaway is simple: dispensary products offer a clear path to a safe and predictable experience, while DIY kits are a project filled with uncertainty.
Opting for dispensary products means choosing certainty over chance. You get a safe, precisely dosed, and convenient experience without the weeks of labor and legal anxiety that come with a DIY spore kit.
This shift toward trusted sources is already happening on a massive scale. The U.S. psychedelic mushroom market was valued at an incredible USD 2.25 billion in 2024, showing just how many people prefer reliable products over the risks of a DIY kit.
As decriminalization continues to expand in places like Detroit and Ann Arbor, more and more consumers are turning to professional, trusted hubs for their needs. This growing demand makes one thing clear: when it comes to psychedelics, safety and convenience are what people want most.
Exploring the Metro Mush Product Menu
Let's be real—fiddling with a magic mushroom spore kit can be a gamble. It takes weeks of work, a sterile environment, and there's always the risk of contamination or just getting a weak harvest. We believe there’s a much simpler way to have a safe, predictable, and powerful experience. That's why we’ve put together a menu of ready-to-go products that skip the hassle of home cultivation entirely.

If you're someone who loves the classic, unaltered mushroom experience, we've got you covered with premium dried strains. Varieties like Penis Envy are a favorite for a reason—they're known for their powerful effects and consistent quality, something you can't ever really guarantee when you're growing your own.
But maybe you're not ready to dive into dried mushrooms just yet. That’s perfectly fine. We’ve found that many people prefer starting with something a little more approachable and precisely dosed.
Approachable and Precisely Dosed Edibles
Our edibles are all about taking the guesswork out of the equation. Each product is crafted for consistency, so you know exactly what you’re getting, every single time. It's the perfect way to manage your experience, whether you're just starting out or fine-tuning a microdosing routine.
- Chocolates: We carry amazing brands like OuterSpore and Mush Love. Their bars are scored into precise doses, making it super simple to go for a gentle microdose or a more profound journey.
- Drinks: Our Rocket Fuel shroom drinks are a game-changer. They offer a unique and refreshing way to get a pre-measured dose without any prep work.
- Specialty Bars: For another tasty option, Moon Bars have become a community favorite for delivering a reliable and enjoyable experience with every piece.
It's clear the interest in psychedelics is exploding. Just look at the market for pre-inoculated mushroom growing kits—the core of many spore kit setups. That industry is expected to grow by USD 328.2 million by 2029. You can learn more about this trend by checking out these insights about the mushroom growing kits market forecast. For us, it just reinforces why we do what we do. Our ready-to-enjoy products offer a much safer, professionally crafted alternative to the DIY path.
How to Get Safe Access in Southeast Michigan
So, you've decided a spore kit isn't for you. Smart move. Getting a safe, reliable experience in Southeast Michigan is actually a lot simpler than you might think, and it doesn't involve the legal gray areas or cultivation headaches. At Metro Mush, we’ve created a clear path for adults to get professionally prepared products. It all starts with a simple text.
We’ve set things up to be as direct and convenient as possible. If you're in the Detroit Metro area, just text your order to (734) 691-6122. For our friends in and around Ann Arbor, the number to use is (734) 280-2868. This is a secure and easy way to connect with our team and get a delivery scheduled when it works for you.
More Than a Dispensary A Community Hub
Here at Metro Mush, we believe that safe access is about more than just a transaction. It's about building a real community. We're not just another delivery service; think of us as a local hub committed to providing adults with products they can trust and rewarding them for being part of our community.
We’re always running promotions designed to give back to our loyal customers and dedicated community members.
- Mix & Match Saturdays: This is a huge fan favorite. You can grab any three of our chocolate bars or shroom drinks for just $100. That can save you up to $40 on your order.
- Service Member Discount: As a thank you for your service, we offer a 10% discount for all fire, police, and military veterans.
- Exclusive Community Savings: Jump into our community on Discord and you’ll unlock an exclusive 20% discount on your orders. It’s also the best place to get the first heads-up on new product drops and flash sales.
Metro Mush provides a trusted, local alternative to the uncertainty of spore kits. With simple text-to-order service, guaranteed product quality, and community-focused discounts, we offer a safe, convenient, and valuable path for adults in Michigan.
At the end of the day, choosing a trusted local provider means putting your safety first and getting a predictable, quality experience. A DIY kit leaves you guessing about potency and legality, but our approach provides clear answers from the start. If you're weighing your options, learning more about the evolving landscape of magic mushrooms in Michigan is a great next step. With our focus on community, value, and safety, Metro Mush is here to serve Southeast Michigan.
Spore Kits: Your Questions Answered
Thinking about buying a magic mushroom spore kit? It's a common starting point for many, but it's important to know what you’re getting into. Let's break down some of the most common questions.
Are Magic Mushroom Spore Kits Even Legal?
This is where things get tricky. The spores themselves don’t actually contain psilocybin, which lands them in a legal gray area. That’s why you’ll often see them sold online for "microscopy purposes" in many states.
However, the moment you decide to germinate those spores and grow mushrooms, you’re crossing a line. Cultivation is illegal under federal law and in most states, including Michigan. Even in cities with decriminalization, like Ann Arbor and Detroit, growing your own can still carry significant legal risks.
How Long Does It Take to Grow Mushrooms from a Kit?
Patience is key here. If everything goes perfectly, you’re looking at a timeline of 4 to 8 weeks from when you first inoculate the growing medium to your first harvest.
But that’s a big "if." First-timers often run into issues with contamination or struggle to maintain the perfect temperature and humidity, which can delay or completely ruin the entire process.
Is It Safe to Eat Homegrown Magic Mushrooms?
Frankly, there are some serious risks. Home grows are incredibly susceptible to contamination from nasty bacteria or molds. Some of these can just ruin your crop, but others can be genuinely toxic if you eat them.
On top of that, potency is a total guessing game. The psilocybin levels can vary wildly from one mushroom to the next, making it nearly impossible to dose accurately and safely.
The bottom line is that home cultivation is unpredictable and risky. Lab-tested products from a trusted dispensary completely eliminate these safety and potency concerns, offering a reliable experience every time.
Ready to skip the risk and uncertainty of a DIY kit? Metro Mush offers a full menu of safe, lab-tested, and precisely dosed products delivered right to your door in Southeast Michigan. Explore our curated selection at https://metromush.com.






